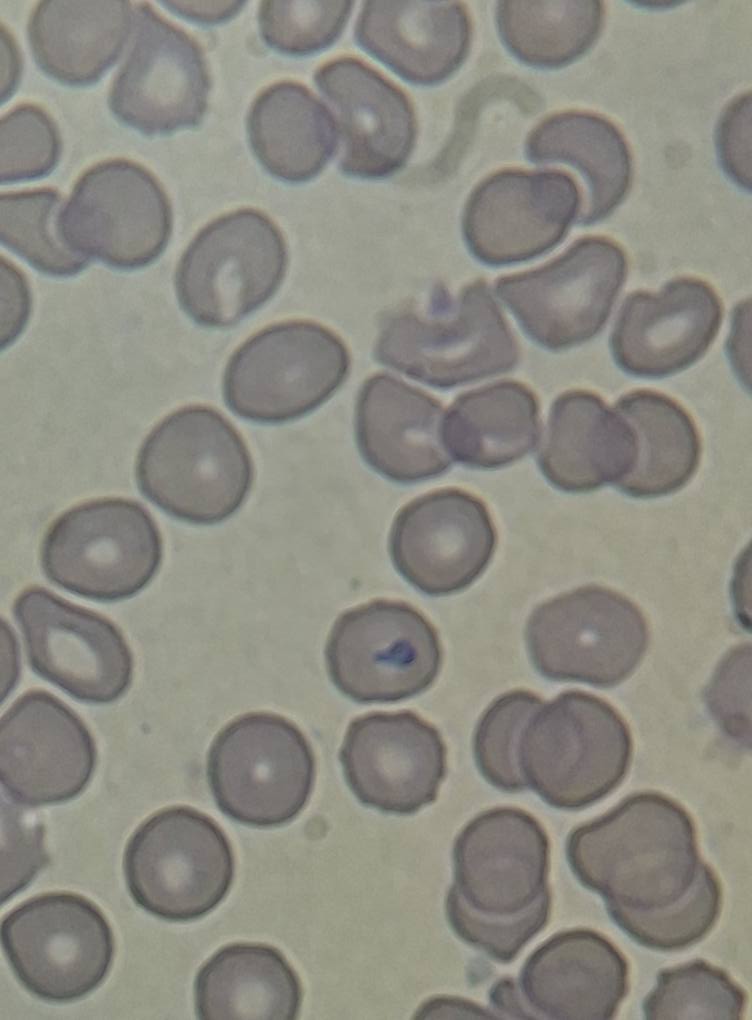

Veterinarska ambulanta
Osnovne informacije
Sve-Pet d.o.o.
Specijalistička veterinarska ambulanta
Tel: 065/648-052
Radno vrijeme: Pon-pet: 9-17h, Sub: 9-12h
Dežurni broj za hitne slučajeve:
066/143-398
Kontakt: Sanjica Katić,
univ. mag. med. vet.
E-mail: vetsvepet@gmail.com